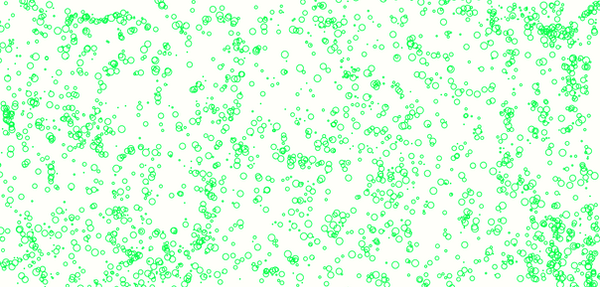

HOME | DD
 angelic-graphics — Texture #11
angelic-graphics — Texture #11

#digitalart #doodle #bubbles #circles #photoshop #procreate #resources #stockimages #texture #texturepack #resourcesstock #resourcepack #resourcesstockimages #texturespack #resourcesphotoshop #deviantart_muro #resourcestock #texturesresources #resourcespack #ibispaintx #black_white_texture
Published: 2024-08-07 13:10:20 +0000 UTC; Views: 1600; Favourites: 6; Downloads: 3
Redirect to original